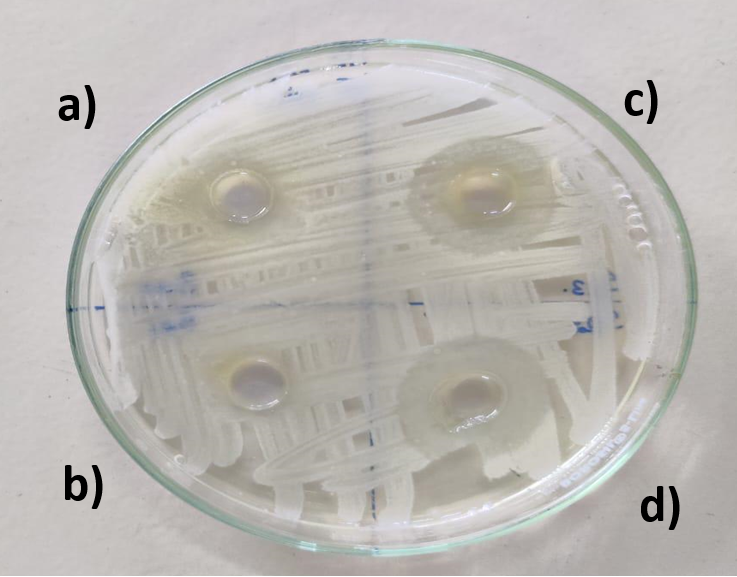

1Nitte (Deemed to be University), NGSM Institute of Pharmaceutical Sciences (NGSMIPS), Department of Pharmaceutics, Mangalore, India. 2Dr. D. Y. Patil Unitech Society’s, Dr. D. Y. Patil Institute of Pharmaceutical Sciences and Research, Pimpri, Pune, India. 3Dr. D. Y. Patil Dnyan Prasad University, School of Pharmacy and Research, Pimpri, Pune, India
*Corresponding author: Sindhoor S. M.; *Email: drsindhoor.sm@nitte.edu.in
Received: 04 Jun 2025, Revised and Accepted: 18 Aug 2025
ABSTRACT
Objective: To prepare and optimise peel-off face mask gel containing silymarin for the management of acne and evaluate its performance in vitro.
Methods: This study established Silymarin's identity using Proton NMR and FTIR. A total of 17 peel-off facemask gels containing silymarin were subsequently prepared as per Box Behnken Design and the influence of the formulation components on the critical evaluation parameters was investigated. The optimised formulation was selected based on criteria of maximum spreadability and minimum drying time. The optimised formulation was then subjected to various in vitro evaluation parameters like organoleptic properties, Physiochemical properties, antioxidant activity, antimicrobial activity and stability studies.
Results: Statistical analysis from the Box Behnken Design (BBD) revealed that ethanol concentration had a significant inverse relationship with drying time (coefficient: –5.56, p<0.0001), while PVA and Carbopol negatively influenced spreadability (p<0.0001). The optimized formulation, containing 6.01% PVA, 0.632% Carbopol, and 8.3% ethanol, exhibited a drying time of 22.56 min and spreadability of 4.25 cm, with a residual error of 5.15% for drying time and 3.19% for spreadability from predicted values and overall desirability of 0.925. The formulation showed desirable organoleptic properties, a viscosity of 7700±435.88 cP, and a pH of 5.45±0.25, making the formulation suitable for topical application. 2,2-Diphenyl-1-picrylhydrazyl (DPPH) scavenging activity confirmed the antioxidant potential of the peel-off facial mask with an IC 75 value of 525µg/ml. Antimicrobial studies showed a 22.1 mm zone of inhibition against S. aureus, comparable to standard clindamycin gel (23.4 mm). In vitro diffusion studies indicated a sustained drug release (68.1% at 24 h) with Korsmeyer–Peppas model fitting (R² = 0.981, n = 0.481), confirming diffusion-based release mechanism. Stability testing confirmed the formulation retained its key properties under room and accelerated conditions for 30 days.
Conclusion: The developed formulation satisfied all the in vitro evaluation criteria for peel-off face mask gels and has potent antioxidant and anti microbial potential. However, further in vivo studies of the formulation in suitable animal models are required to validate its therapeutic efficacy.
Keywords: Silymarin, Peel off face mask gel, Box behnken design, Antioxidant, Facial acne
© 2025 The Authors. Published by Innovare Academic Sciences Pvt Ltd. This is an open access article under the CC BY license (https://creativecommons.org/licenses/by/4.0/)
DOI: https://dx.doi.org/10.22159/ijap.2025v17i6.55416 Journal homepage: https://innovareacademics.in/journals/index.php/ijap
Acne vulgaris is one of the most common chronic inflammatory skin conditions that affects people of all ages, especially adolescents. The key factors that play a role in the pathogenesis of acne include increased sebum production, Bacterial colonisation, especially Cutibacterium acne and Staphylococcus aureus, oxidative stress and inflammatory responses [1, 2]. Even though the condition is not life-threatening, acne severely impacts the psychological well-being of the affected individuals, leading to a lack of self-confidence, social isolation and depression [3]. Various medications are available for managing acne, such as benzoyl peroxide, antibiotics and retinoids [4]. However, all these medications have only a modest efficacy and numerous side effects. Additionally, due to the global increase in antibiotic resistance, the use of antibiotics as monotherapy for acne is discouraged.
Recently, there has been a renewed interest in phytomedicines as an alternative therapy for the management of acne. Among the various plant-based medicines explored for anti-acne activity, silymarin has interested researchers due to its antioxidant, free radical scavenging, and anti-inflammatory activity [5]. Silymarin reduces the pro-inflammatory mediators released by Cutibacterium acne, scavenges the released free radicals, and reduces oxidative stress, thus playing a key role in reducing the factors responsible for the pathogenesis of acne [6]. In this context, silymarin can be considered a key therapeutic option in managing acne.
A Peel off face mask gel is one of the suitable skin care products that can be used for facial-related conditions such as acne [7]. It is applied as a gel onto the skin, which, upon drying, forms a thin and transparent elastic malleable layer that can be peeled off [8]. These formulations can also help to shrink pores and increase the impact of the active constituents on the skin due to the barrier created by the plastic film. Moreover, they moisturise the skin and make it clean and firm due to the occlusive nature of the polymer used in the film [9].
In this work, the response surface methodology (RSM) approach, based on Box Behnken Design(BBD) was used to analyse the impact of various formulation variables on the essential properties of peel-off face mask gel and thus optimise the final formulation. The Box Behnken design was chosen among the various RSM designs since it is easier to determine variable comparisons in experiments with minimum runs [10].
Based on these considerations, an attempt was made in this study to prepare a peel-off face mask gel containing silymarin using the RSM approach for the management of facial acne. The association of silymarin in a peel-off face mask gel is expected to lead to the development of a natural skin care product that is easily applicable and commercially viable.
Materials
Silymarin was procured from Yarrow Chem Products, Dombivali, Mumbai, India. Polyvinyl alcohol (PVA), Propylene glycol, methylparaben, Carbopol 934 P NF, Ethanol, DPPH (analytical grade), Nutrient agar and triethanolamine were purchased from HiMedia Laboratories Pvt. Ltd., Mumbai, India. All other chemicals and reagents used were of analytical grade.
Methods
Identification of silymarin by FT-IR
Fourier Transform Infrared Spectroscopy (FTIR) was used to identify functional groups in silymarin with the help of an ATR (Attenuated Total Reflectance) accessory. Initially, the background measurements were taken with an empty ATR accessory. A small quantity of silymarin was then placed on the ATR crystal, and the spectrum was recorded between 500-4000 cm-1 at 4 cm-1 resolution [11].
Identification of Silymarin by NMR spectroscopy
Nuclear magnetic resonance (NMR) spectroscopy is an analytical technique used to determine a compound's molecular structure by observing the magnetic properties of atomic nuclei. The ¹H and ¹³C NMR spectra of silymarin were recorded in DMSO (dimethyl sulfoxide)-d6 using a 400MHz spectrometer at NMR Lab Services, Mangalore University, Mangalore.
Preparation of Silymarin-based peel-off facial mask gel
The base formula for the preparation of the face mask is shown in table 1 was established based on a literature survey, and the ingredients' concentration was determined based on screening studies. Only the concentrations of the key ingredients were varied as per the experimental design, as shown in table 2. The preparation method remained the same for all the formulations, with only a difference in the concentration of the ingredients used.
Initially, distilled water was heated in a beaker at 80 °C, followed by adding Poly Vinyl Alcohol(PVA) with continuous stirring to obtain the dispersion. The PVA dispersion was then subjected to homogenisation until the PVA was dissolved completely, and a clear solution was obtained. In another beaker containing the remaining portion of distilled water, propylene glycol and Carbopol were added. The PVA solution was then added to the Carbopol solution. To the resultant mixture, weighed quantities of silymarin (0.05g) dissolved in about 8 ml of ethanol and propyl paraben were added. Triethanolamine was added to the final mixture to adjust the pH to a near-neutral range. The prepared formulation was then undisturbed for 72h to allow for the removal of air bubbles and allow sufficient time for polymer hydration before any evaluations were carried out.
Experimental design
A Box Behnken Design was used to statistically assess how different formulation variables impact the performance of the peel-off face mask gel. The three formulation variables which had a significant effect on the peel-off facial mask gel and their ranges were selected based on screening studies. These values were entered in the Design Expert software®(Version 7, Stat-Ease Inc., Minneapolis, MN, USA) and the software generated 17 runs with five centre points. Table 2 shows the three formulation variables along with their responses.
Table 1: Composition of silymarin peel-off facemask gel
| Ingredients | Quantity (%w/w) | Use |
| Silymarin | 0.05 | Active ingredient |
| Polyvinyl alcohol | 6-14 | Film-forming agent |
| Carbopol 934 P NF | 0.5-2.5 | Gelling agent |
| Ethanol | 1-10 | Solvent/Solubliser |
| Propylene glycol | 3 | Humectant |
| Methyl paraben | 0.1 | Preservative |
| Triethanolamine | 0.2 | pH adjuster |
| Distilled water | q. s. | q. s. |
Table 2: Formulation variables and their levels considered for Box Behnken design
| Formulation variables | Levels | ||
| Low(-1) | Medium(0) | High (1) | |
| Polyvinyl Alcohol (PVA) (%) | 6 | 10 | 14 |
| Carbopol (%) | 0.5 | 1.5 | 2.5 |
| Ethanol (%) | 1 | 5.5 | 10 |
| Responses | Constraints | ||
| Drying Time | Minimise | ||
| Spreadability | Maximise | ||
Characterisation of peel-off facial mask gel
Organoleptic properties
Evaluation of organoleptic properties such as visual appearance, colour and odour of the face mask was carried out to determine the aesthetic appeal of the formulation. The colour of the preparation was evaluated by observing it in bright light, whereas the odour was checked by smelling the preparation for its fragrance.
Homogeneity
Homogeneity was initially evaluated by placing a small quantity of the gel between two glass slides and visually observing for the presence of lumps, aggregates, or phase separation microscopic image analysis of the gel was carried out to observed any internal consistency and particle distribution [12].
pH
The formulation's pH was measured using a digital pH meter (Eutech Instruments pH 700, Singapore), the recordings were taken in triplicate, and the average reading was considered. Before carrying out the measurement, the pH meter was calibrated using standard buffer solutions at pH 4.0, 7.0, and 10.0, respectively.
Drying time
To evaluate the time the facemask gel took to dry, a weighed amount of gel was placed on a glass plate and spread evenly, forming a uniform mask layer. The plate was then incubated at 37 °C±0.5 °C to simulate the skin temperature. The formulation was observed every 5 min till the surface of the facemask was dried completely. Three such measurements were carried out, and the average value was recorded [13]. The study was conducted under ambient laboratory humidity conditions (Relative Humidity: 40–50%), but RH was not actively controlled.
Spreadability
To assess the spreadability, an accurately weighed quantity of the formulation (1g) was placed at the center of a glass slide having the dimensions (7.5 cm × 2.5 cm) glass slide and a second glass slide having the same dimensions was placed right above the primary slide. A fixed weight of 100 g was placed on the glass slide, and the formulation was allowed to spread for about a minute. The weight was removed, and the diameter of the formulation was measured using a stainless steel ruler with 1 mm precision to evaluate the spreadability. The procedure was repeated three times, and results were recorded as mean±SD, and Spreadability was reported as the diameter of the circular spread zone (cm) [14].
Viscosity
The viscosity of a formulation indicates the difficulty of flowing through it, and in order to assess the flow behaviour of the facemask gel, viscosity was measured at spindle speeds ranging from 0.5-50rpm using Spindle no 64 at 25 °C±0.5 °C [15].
Extrudability
Extrudability measurement is essential to understand the ease with which the gel formulation can be extruded from the tubes. The assessment was carried out by transferring a weighed amount of the sample into a collapsible tube with a standard nozzle having a diameter of 5 mm. After the formulation was loaded onto the tube, a known weight was placed at the crimp of the tube, and the cap was opened, allowing the contents to flow freely. The extruded formulation was weighed and calculated for extrudability percentage [16]. The formula for calculating the extrudability is as follows.
Extrudability (%) = (weight extruded/total weight loaded) *100
Antioxidant activity
The antioxidant activity of the silymarin face mask gel was evaluated using the 2,2-diphenyl-1-picrylhydrazyl (DPPH) radical scavenging assay. A 0.1 mmol DPPH solution in methanol was prepared/and a known quantity of silymarin gel was equivalent to 200-500µg of silymarin was taken and vortexed with methanol to ensure a homogenous dispersion and mixed with 1 ml of 0.1 mmol DPPH solution. Then, the reaction mixture was kept in the dark for 30 min. Absorbance was measured at 517 nm using an ELISA reader. Methanol containing DPPH served as the blank. The percentage of DPPH inhibition was calculated using the formula [17]. IC75 values were determined from the regression equation for % inhibition vs. concentration curve for both pure silymarin and the formulated gel.

Antimicrobial activity of silymarin
The antimicrobial activity of peel-off facial mask gel against Staphylococcus Aureus (ATCC 25923) was evaluated. Briefly, 7g of nutrient agar was dissolved in 250 ml of distilled water and sterilised using an autoclave for 30 min at 121 °C. The agar medium was cooled to 40-45 °C, and 20 ml of the solution was poured into the sterilised petri plates in a sterile area and incubated 37±1 °C for 24 h. Bacterial cultures were adjusted to 0.5 McFarland standard (~1.5 × 10⁸ CFU/ml) prior to inoculation on nutrient agar plates. After incubation, the microorganisms were spread upon the solidified agar medium using sterilised inoculum, and the microorganisms were incubated for 1 d to form bacterial colonies. After the colonies were formed, four wells were created using a sterile cork borer, to which 1 ml of the blank solution, Placebo face mask gel, Optimised peel-off facial mask gel and marketed Clindamycin gel (1%w/w) were added and incubated for 1 day 37 ± 1 °C and observed for the zone of inhibition [18]. The average size of the zone of inhibition was assessed.
In vitro drug diffusion studies
In vitro drug diffusion studies of silymarin peel-off face mask gel and silymarin hydrogel without film-forming agents were carried out using a Franz diffusion cell with an area of 1.772 cm2 and a receptor compartment with a capacity to hold 12 ml of liquid. Phosphate buffer saline(PBS), having a pH of 7.4, served as the diffusion medium since silymarin was freely soluble in the aqueous PBS 7.4 Solution. The cellophane dialysis membrane (MWCO 12–14 kDa, HiMedia®, India) was pre-soaked in PBS pH 7.4 for 30 min prior to use. The membrane integrity was confirmed by visual inspection for uniformity and absence of perforations and leakage before assembly. The receptor chamber was filled with 12 ml PBS (pH 7.4) maintained at 37 ± 0.5 °C and stirred at 400 rpm. To estimate the drug release, 1g of the facemask gel was placed on the cellophane dialysis membrane between the donor and receptor compartments. At predetermined intervals for up to 24h, 1 ml of the receptor medium was withdrawn and replenished with the 1 ml of PBS to maintain the sink condition. The withdrawn samples were analysed for the drug content using a UV spectrophotometer (UV-1601 Shimadzu, Japan) at 287 nm [19, 20, 27]. The drug release data was then fitted into various mathematical models like Zero order, first order, Higuchi and Korsmeyer–Peppas and the model having the highest regression coefficient (R2) was considered as the best fit.
Physicochemical stability
Three samples of the optimised peel-off mask gel were stored in polyethene bottles at 5±1 °C (low temperatures, 22±1 °C (room temperature) and 45±2 °C (Accelerated temperature), respectively. The samples were analysed after 30 days for the organoleptic properties (Colour, order, Homogeneity), Drying time, pH, Spreadability, Extrudability and Viscosity, and the values were recorded. An average of three measurements were considered.
Identification of silymarin
The identity of the silymarin was confirmed by FTIR and NMR techniques. As observed in FTIR spectra shown in fig. 1, silymarin functional peaks were obtained at 3396.73 (O–H stretching), 2927.12 (Carbon-hydrogen bonds, C–H stretching), 1709.04(Carbonyl groups, C=O stretching, esters), 1633.59 (Amide groups, C=O stretching), 1509.72 (C-O stretching), 1459.78(alkanes group, C-H bending), 1362.60 C-H bending (alkanes group), 1267.15, 1024.73, 1160.56 (C-O alcohol), 734.43, 633.59 cm-1 (C-H aromatics group).
Further, the proton NMR spectra of silymarin as shown in fig. 2, depict the presence of twenty-two protons in the structure. The most deshielded proton of the hydroxyl group exhibited a singlet at δ 11.88 ppm attached to a (C-5) benzene ring adjacent to fused tetrahydro-pyran-one [29]. The peaks for C-7 and C-3 hydroxyl groups protons were observed at δ 9.13 and δ 10.84 ppm. The multiplet peaks were depicted for aromatic hydrogens atoms present in two benzene rings at δ 6.75–7.09 ppm. The singlet peak for the proton of the methoxy group was observed at δ 3.78 ppm attached to C-12 of the benzene ring system. The proton of the methine group present in the pyranone and dioxane showed a chemical shift from δ 5.01 to δ 5.88 ppm. These results confirmed the silymarin identity.
Experimental design
While considering the different responses that affect the performance of the peel-off face mask gel, drying time and spreadability were chosen as crucial factors that affect the quality of the formulation. In the case of peel-off facial mask gel, the film must dry as quickly as possible upon application of the formulation. Polyvinyl alcohol and ethanol were considered formulation variables since they most impact the drying time. Spreadability is another essential response that was chosen since it impacts the applicability of the formulation. Face mask gels having poor spreadability will be challenging to apply and will impact customer satisfaction
.n, failing commercialisation. The parameter that influences this response is the concentration of the Carbopol. Thus, PVA, Ethanol and Carbopol were chosen as independent variables, with the responses being drying time and spreadability.
Each formulation was prepared and evaluated in triplicate to ensure reproducibility. The results reported in table 3 are expressed as mean±standard deviation (SD) for each response (Drying Time and Spreadability). The statistical analysis of these response variables is provided in table 4.
Influence of formulation variables on the drying time
As shown in table 4 and fig. 3, only ethanol concentration significantly impacted the drying time. Ethanol had a negative coefficient of -5.56, indicating that ethanol concentration was inversely proportional to the drying time. This can be attributed to the volatile nature of ethanol, which acts as a drying enhancer and also evaporates faster than water. Furthermore, PVA concentration positively affected the drying time, which means that an increase in PVA concentration leads to longer drying times. This observation is because PVA acts as a plasticiser and interacts with water to form a thick mass, making it difficult for the water to evaporate, which causes the mask to fail to dry out quickly [21].

Fig. 1: FTIR spectra of pure silymarin

Fig. 2: Proton NMR spectra of pure silymarin
Table 3: Responses recorded for box behnken design
| Formulations | Factors | Responses | |||
| A: PVA (%) | B: Carbopol (%) | C: Ethanol (%) | Drying time (min)* | Spreadability (cm)* | |
| F1 | 10 | 1.5 | 5.5 | 30.5±0.8 | 4.05±0.10 |
| F2 | 6 | 2.5 | 5.5 | 28±0.7 | 3.72±0.11 |
| F3 | 10 | 1.5 | 5.5 | 27.5±0.6 | 4±0.09 |
| F4 | 10 | 2.5 | 10 | 33±0.9 | 3.65±0.12 |
| F5 | 6 | 0.5 | 5.5 | 25.5±0.6 | 4.38±0.08 |
| F6 | 10 | 1.5 | 5.5 | 29±0.8 | 4.05±0.10 |
| F7 | 10 | 1.5 | 5.5 | 31.5±0.9 | 4.03±0.11 |
| F8 | 6 | 1.5 | 1 | 36±1.0 | 4.1±0.12 |
| F9 | 6 | 1.5 | 10 | 22±0.7 | 4.22±0.10 |
| F10 | 14 | 1.5 | 10 | 28±0.9 | 3.9±0.11 |
| F11 | 10 | 2.5 | 1 | 40±1.0 | 3.6±0.13 |
| F12 | 10 | 1.5 | 5.5 | 30±0.7 | 4.02±0.10 |
| F13 | 10 | 0.5 | 10 | 23.5±0.6 | 4.3±0.09 |
| F14 | 14 | 2.5 | 5.5 | 35±1.1 | 3.58±0.14 |
| 15 | 14 | 1.5 | 1 | 37±0.9 | 3.92±0.10 |
| 16 | 10 | 0.5 | 1 | 38±1.0 | 4.28±0.12 |
| 17 | 14 | 0.5 | 5.5 | 27±0.7 | 4.18±0.10 |
*value are expressed as mean±SD (n = 3)
Table 4: ANOVA analysis, significant model term and regression coefficient values for the responses
| Drying time (Quadratic model) | Spreadability (Quadratic model) | |||
| Polynomial term | Coefficient | P value | Coefficent | Pvalue |
| Model | <0.001 | <0.001 | ||
| Intercept | 29.70 | 4.03 | ||
| A-PVA | 1.94 | 0.0025 | -0.1050 | <0.0001 |
| B-Carbopol | 2.75 | 0.0003 | -0.3237 | <0.0001 |
| C-Ethanol | -5.56 | <0.0001 | +0.0212 | 0.0737 |
| AB* | 1.37 | 0.0548 | +0.0150 | 0.3290 |
| AC* | 1.25 | 0.0746 | -0.0350 | 0.0443 |
| BC* | 1.87 | 0.0164 | +0.0075 | 0.6161 |
| A²* | -1.85 | 0.0155 | +0.0062 | 0.6674 |
| B²* | 1.02 | 0.1217 | -0.0713 | 0.0014 |
| C²* | 2.90 | 0.0016 | -0.0012 | 0.9310 |
| R2 | 0.9767 | 0.9941 | ||
| Adjusted R2 | 0.9467 | 0.9864 | ||
| Predicted R2 | 0.9404 | 0.9319 | ||
| Adequate Precision | 19.7162 | 39.0949 | ||
*AB: Interaction between PVA and Carbopol, AC: Interaction between PVA and Ethanol, BC: Interaction between Carbopol and Ethanol, A2: Quadratic term for PVA, B2: Quadratic term for Carbopol, Quadratic term for ethanol



Fig. 3: Contour plots depicting the combination effect of formulation variables on the drying time
Influence of formulation variables on the spreadability
One of the key factors determining the applicability of peel-off facemask gel is its spreadability. As seen in table 4 and fig. 4, the PVA and Carbopol concentrations had a significant negative effect on the spreadability of the facemask gel, whereas ethanol concentration had a positive effect, even though it was not significant. This can be explained by the fact that the higher the PVA concentration, the greater the viscosity due to hydrogen bonding between the OH group of PVA and the aqueous vehicle used in the formulation; consequently, there is a decrease in the spreadability. Also, an increase in the Carbopol concentration makes the formulation thicker and results in formulations with poor spreadability. Thus, formulations with low concentrations of PVA and carbopol lead to fluidity, and formulations with high concentrations of PVA and carbopol lead to thick formulations. Hence, an intermediate range is preferred for optimal spreadability and applicability [22].



Fig. 4: Contour plots depecting the combination effect of formulation variables on the spreadability
Optimisation of peel-off facemask gel
The peel-off facemask gels were optimised using the numerical optimisation option in the Design Expert software®. The criterion for optimization was based on minimum drying time and maximum spreadability. In the case of formulation variables, the criteria for ethanol concentration were set to minimum as higher ethanol concentrations cause skin irritation. During the numerical optimization, spreadability was assigned a higher importance level (5) to maximize its value, while drying time was assigned a moderate importance level (3) to minimize it. These priorities were based on the formulation’s ease of application and patient compliance after applying the constraints on spreadability and drying time, the design expert software suggested the optimal formulation with an overall desirability value of 0.925. Desirability values of more than 0.9 are considered acceptable. The suggested formulation was then prepared and evaluated to check the validity of the predicted responses. The difference between the predicted and observed responses was negligible and their residual errors were less than within the limit as shown in table 5, demonstrating the validity of the optimisation process and robustness of the model used. The optimised formulations were then selected for further investigations.
Table 5: Point prediction of the optimised peel-off facial mask
| PVA (%) | Carbopol (ml) | Ethanol (%) | Drying time (min) | Spreadability (cm) | Overall desirability | |
| Predicted responses | 6.000 | 0.614 | 5.000 | 21.4 | 4.390 | 0.925 |
| Actual Responses | 22.56 | 4.25 | ||||
| Residual error (%) | 5.15 | 3.19 |
Evaluation of the optimised peel-off facemask gel
Physiochemical properties
The developed peel off mask gel demonstrated physiochemical properties that are comparable to the marketed topical anti-acne formulations. The optimised peel-off facemask gel was observed to be slightly yellowish with a semi-solid consistency and did not have any unpleasant odour. The formulation had no lump formation or presence of any aggregates, and there were no signs of sedimentation, indicating its homogeneous nature. Microscopic examinations of the gel revealed the consistent nature of the gel without any major lumps, as shown in fig. 5. Microscopic or rheological measurements (e. g., shear stress, yield point) would provide a more robust evaluation. These parameters are recommended for future in-depth studies to support product quality claims the optimised formulation had a near-neutral pH of 5.45±0.25, which is close to the skin pH range, indicating that the formulation meets expectations of a topical formulation as being non-irritant to the skin. It is expected that a peel-off facial mask should dry in 15-30 min after application. The optimised peel-off facial mask had a drying time of 22±1 min which is within the range observed for marketed peel off facial mask and the masks could be peeled off without any signs of tearing or cracking. The spreadability of the facemask gel depends on the force applied, the duration of application, and the gel thickness. The peel-off face mask was found to be easily spreadable without any resistance, as indicated by its spreadability value, which is shown in table 6. The spreadability value reported as the diameter of the spread gel layer was within the 4-7 cm range observed for peel-off face mask gels [28]. Further, the viscosity of the peel off face mask was found to be slightly lower than that of a commercially available peel-off face mask; however, this facilitated the easy spreading of the face mask gel without compromising the film strength. It was observed that the viscosity of gel decreased with an increase in rpm (shear rate), indicating that gel displayed pseudoplastic flow behaviour as shown in fig. 6. The pseudoplastic flow behaviour is ideal for facemask gel because it allows easier spreading of the gel with mild force at the same time maintaining its consistency at rest. The values obtained for viscosity, as indicated in table 6, were in line with the reported literature for peel off face mask gel. The percentage of extrudability shown in the table of the gel formulation indicates that the gel can be easily extruded from the gel upon applying a moderate force.

Fig. 5: Microscopic Image of the optimized peel off face mask gel at 45X, indicating uniform consistency of the gel
Table 6: Physicochemical properties of the optimised peel-off face mask gel
| Parameters | Observation |
| Colour | Slightly Yellowish |
| Odour | Odourless |
| Homogeneity | No Aggregates |
| pH* | 5.45±0.25 |
| Drying time (min)* | 22±1 |
| Viscosity (Cp)*• | 7700±435.88 |
| Spreadability (cm)*# | 4.2 ±1.3 |
| Extrudability*(%) | 10.2±0.2% |
*Data are expressed as mean±SD (n=3), #Spreadability values represent the diameter (in cm) of gel spread after 1.0 g of sample was pressed between two glass slides under a 100 g weight for 1 min, • Viscosity measured at 10 rpm with Spindle no 64 at 25±0.5 °C

Fig. 6: Viscosity of the optimized peel off face mask gel at different Shear rates (0.5-50rpm) using spindle no 64
Antioxidant activity
One of the primary factors linked with acne is oxidative stress, which leads to a cascade of inflammatory processes that lead to the development of acne. In this context, it is essential for any formulation meant to treat acne to have antioxidant potential. Thus, the antioxidant potential of the optimised peel off facial mask gel was assessed by DPPH radical scavenging assay. This assay is based on the fact that when DPPH, a free radical molecule, reacts with antioxidant chemicals via the process of H atom donation, it changes colour from purple to pale yellow, as determined by a UV-vis spectrophotometer set at 517 nm. The greater the free radical potential of the compound, the greater the antioxidant activity. The antioxidant activity of the optimized peel-off facial mask gel was assessed using the DPPH radical scavenging assay and compared with pure silymarin. As shown in fig. 7 the gel formulation containing 0.05% w/w silymarin, demonstrated a DPPH scavenging activity of 70.27% when 1 g of formulation (equivalent to 500 µg of silymarin) was tested. In comparison, pure silymarin exhibited 84% scavenging at the same concentration (500 µg/ml). Also, IC 75 values of pure Silymarin was found to be 345µg/ml, whereas for the formulation, it was 525µg/ml. From the results, it can be inferred that the activity appears slightly lower in the formulation, This is expected due to the encapsulation of silymarin within the polymeric gel matrix, which may reduce immediate availability. Nevertheless, the formulation retained a significant portion of silymarin's antioxidant potential, indicating that the gel matrix does not substantially hinder the radical scavenging efficacy.

Fig. 7: DPPH scavenging assay of pure silymarin and silymarin peel-off facial mask
Antimicrobial activity
The test results shown in fig. 8, revealed that all the tested samples could successfully inhibit the growth of S. Aureus. Among the tested samples, the standard Clindamycin gel exhibited the largest zone of inhibition at 23.4 mm±0.5 mm, confirming its strong antimicrobial effect. Whereas the optimised peel-off facemask had an inhibition zone of 22.1 mm±1 mm. One-way ANOVA analysis of the data revealed that there was no significant difference between the marketed and silymarin formulations(p<0.05), demonstrating comparable potential of both the formulations against S. Aureus. The control and Placebo formulation did not show any inhibition. The findings align with the literature, suggesting that silymarin exerts antibacterial activity by altering bacterial cell membrane permeability and adhesion [23, 24]. By their polyphenolic nature, they are also believed to suppress the metabolic process in bacteria and prevent ATP and DNA biosynthesis required for bacterial growth [25, 26]. These results suggest potential antimicrobial benefits, though MIC (Minimum Inhibitory Concentration)/MBC (Minimum Bactericidal Concentration) data will be required to confirm potency and therapeutic relevance.
Fig. 8: Images depicting the inhibition zone of a) Control (no treatment) b) Placebo peel off face mask gel c) Optimised peel off face mask gel d) Clindamycin gel (Marketed formulation)
In vitro drug diffusion studies
The results obtained from the comparative diffusion study performed between the optimized silymarin peel-off gel formulation and a silymarin hydrogel without film-forming agents is shown in fig. 9. The hydrogel released silymarin significantly faster, achieving 64.7% release at 6 h and 93.6% at 24 h, compared to 35.8% and 68.1% for the peel-off gel. This difference in drug release at the same time intervals indicates that sustained release potential of the peel-off gel, attributed to the polymeric matrix of PVA and Carbopol, which delays drug diffusion by forming a semi-occlusive film. These findings indicate that a simple hydrogel form of silymarin may be useful for rapid onset of action; however, for conditions such as acne where patient compliance is necessary, the peel-off facial mask gel with its sustained release effect helps to reduce dosing frequence and will enhance the skin contact due to the occlusive effect of film-forming agents. These findings are supported by reported literatures, which suggest that PVA enhances film strength and adhesion, while Carbopol influences rheology and release rate, both contributing to controlled drug delivery within the limited application window [21, 22]. Although the peel-off gel formulation is removed from the skin after approximately 22 min, the sustained release behaviour observed in vitro is still relevant. This is because drug diffusion into the upper layers of the stratum corneum begins immediately upon application and continues as long as the formulation is in contact with the skin. However, further ex vivo studies or studies carried out using Strat M membrane can only confirm this phenomenon mere in vitro data is not sufficient. Kinetic analysis of the release showed that regression coefficient for Korsmeyer–Peppas model in the case of silymarin facemask gel was 0.981 with n value of 0.481, suggesting a anomalous (Non-Fickian) diffusion where drug release is governed by both diffusion and matrix relaxation. This aligns with the use of PVA and Carbopol, which form a semi-occlusive film, sustaining silymarin release.

Fig. 9: In vitro diffusion of silymarin from hydrogel and peel off face mask gel carried out in Franz diffusion cell using Phosphate buffer 7.4S as the diffusion medium
Physiochemical stability
As observed from table 7, there were no changes in most of the evaluated parameters at low and room temperatures. At cold conditions, slight aggregation was seen in the gel formulation compared to Room and Accelerated conditions, which may indicate phase separation or polymer aggregation under low temperature. However, this clumping was partially reversible upon gentle mixing. Also, at accelerated conditions, the formulations dried slower due to the evaporation of ethanol, which also increased the viscosity of the formulation, making it difficult to spread the gel. Thus, the formulation can be stored best at room temperature without affecting its stability and the formulation may not be suitable for cold climatic conditions.
Table 7: Stability studies of the optimised facemask gel at different storage conditions
| Parameters | Temperature conditions | ||
| Cold (5±1 °C) | Room (22±1 °C) | Accelerated (45±1 °C) | |
| Colour | Slightly Yellowish | Slightly Yellowish | Slightly Yellowish |
| Odour | Odourless | Odourless | Odourless |
| Homogeneity | Slight clumps | No Aggregates | No Aggregates |
| pH* | 5.41±1.41 | 5.47±0.25 | 4.95±1.08 |
| Drying time (min) | 21 | 24 | 35 |
| Viscosity (cp)* | 7674±11 | 7700±23 | 8210±21 |
| Spreadability (cm)* | 4.1 ±0.89 | 4.2 ±1.3 | 4.2 cm±1.5 |
| Extrudability | 10.5% | 10.2% | 10.4% |
*Data are expressed as mean±SD (n=3)
In this study, silymarin was identified using modern analytical techniques such as FTIR and NMR. The individual influence of formulation variables on the responses and their combination effect was assessed with the help of response surface plots and ANOVA analysis. The analysis showed that ethanol concentration significantly impacted drying, whereas PVA and carbopol significantly affected spreading time. The negligible difference between predicted and actual responses demonstrated the robustness of the design mode. The optimised face mask gel formulation had an aesthetic appearance without any foul odour. Moreover, the formulation had a neutral pH and had good applicability. Further, the viscous nature of the preparation enables the sustained release of silymarin, as is evident from the in vitro diffusion studies. Although the optimized peel-off antioxidant activity and inhibition effect of the formulation against S. Aureus make it promising for managing facial acne, further studies in cytokine inhibition essays for IL-6, TNF alpha which are involved in acne physiology along with in vivo evaluation in acne models, are needed to comprehensively validate the therapeutic efficacy of the formulation. Further, as the optimized formulation contains ethanol as a permeation enhancer, future studies involving skin irritation assays and human patch testing are necessary to assess the dermatological safety of the formulation, particularly in the sensitive skin population.
The authors thank NGSM Institute of Pharmaceutical Sciences, Nitte (Deemed to Be University) for providing the necessary study facilities.
The studies did not receive any funding from any sources.
Sindhoor S M contributed to the study design, Data analysis, and Manuscript writing. Gladyston Netto reviewed the manuscript and carried out analytical studies. Vaishnavi, Silna Sasi and Sharma Abhishek Ramvriksh collected the materials and performed the formulation experiments.
The authors declare that no competing interest is involved
Williams HC, Dellavalle RP, Garner S. Acne vulgaris. Lancet. 2012 Jan 28;379(9813):361-72. doi: 10.1016/S0140-6736(11)60321-8, PMID 21880356.
Thiboutot DM, Dreno B, Abanmi A, Alexis AF, Araviiskaia E, Barona Cabal MI. Practical management of acne for clinicians: an international consensus from the global alliance to improve outcomes in acne. J Am Acad Dermatol. 2018 Feb;78(2)Suppl 1:S1-S23.e1. doi: 10.1016/j.jaad.2017.09.078, PMID 29127053.
Griffiths C, Barker J, Bleiker T, Chalmers R, Creamer D. Neoplastic proliferative and infiltrative disorders affecting the skin part 12. In: Bewley A, Calonje E, Griffiths T, Jemec GB, Levell NJ, editors. Rook’s textbook of dermatology. 9th ed. Vol. 4. Chichester, UK: Wiley-Blackwell; 2016. p. 3620-67.
Rathi SK. Acne vulgaris treatment: the current scenario. Indian J Dermatol. 2011 Jan;56(1):7-13. doi: 10.4103/0019-5154.77543, PMID 21572783.
Karimi G, Vahabzadeh M, Lari P, Rashedinia M, Moshiri M. “Silymarin,” a promising pharmacological agent for treatment of diseases. Iran J Basic Med Sci. 2011 Jul-Aug;14(4):308-17. PMID 23492971.
Atallah DA, Badran AY, Makhlouf AG, Mekkawy MM. Topical silymarin cream as a novel therapy versus salicylic acid peels in acne vulgaris: a split-face clinical trial. J Cutan Med Surg. 2024 Jan-Feb;28(1):22-8. doi: 10.1177/12034754231211568, PMID 37942562.
Salmannejad F, Qorab H, Ghari T. Formulation characterisation and optimisation of peel off gel of soybean extract as a face mask. Trop J Nat Prod Res. 2024;8(3):6544-51. doi: 10.26538/tjnpr/v8i3.11.
Zarwinda I, Fauziah F, Jumirna J, Adriani A. The formulation of peel off mask from the ethanol extract of bilimbi leaves (Averrhoa blimbi L.) as an anti-acne treatment. LJ. 2021;9(1):499035. doi: 10.22373/lj.v9i1.10206.
Baby AR, Zague V, Maciel CP, Salgado Santos IM, Kawano Y, Areas EP. Development of cosmetic mask formulations. Rev Bras Cienc Farm. 2004 Apr;40(2):159-61.
Nur S, Sami FJ, Sapra A, Aisyah AN, Burhan A, Megawati. Application box–behnken design for the optimum cream formula of Muntingia calabura fruit extract: in vitro and in vivo studies as an antiaging product. Res J Pharm Technol. 2024;17(11):5325-35. doi: 10.52711/0974-360X.2024.00815.
Alshehri FS, Kotb E, Nawaz M, Al Jameel S, Amin KA. Preparation, characterization and antibacterial competence of silymarin and its nano-formulation. J Exp Nanosci. 2022;17(1):100-12. doi: 10.1080/17458080.2022.2041192.
Rosaini H, Makmur I, Lestari EA, Sidoretno WM, Yetti RD. Formulation of gel peel-off catechins mask from gambir (Uncaria gambir (Hunter) Roxb) with the PVP K-30 concentration variation. Int J Res Rev. 2021;8(3):205-11.
Beringhs AO, Rosa JM, Stulzer HK, Budal RM, Sonaglio D. Green clay and aloe vera peel-off facial masks: response surface methodology applied to the formulation design. AAPS PharmSciTech. 2013 Jun;14(1):445-55. doi: 10.1208/s12249-013-9930-8.
Khullar R, Kumar D, Seth N, Saini S. Formulation and evaluation of mefenamic acid emulgel for topical delivery. Saudi Pharm J. 2012;20(1):63-7. doi: 10.1016/j.jsps.2011.08.001, PMID 23960777.
Syakri S, Ismail I, Amal NM, Masjidi NA, Tahir KA. Characterization and anti-aging tests of peel-off gel masks made from ethanolic extract of yarrow (Achillea millefolium). Maced J Med Sci. 2021 Oct 8;9(B):1156-61. doi: 10.3889/oamjms.2021.7574.
Naga Sravan Kumar Varma V, Maheshwari PV, Navya M, Reddy SC, Shivakumar HG, Gowda DV. Calcipotriol delivery into the skin as emulgel for effective permeation. Saudi Pharm J. 2014 Dec;22(6):591-9. doi: 10.1016/j.jsps.2014.02.007, PMID 25561873.
Anthony KP, Saleh MA. Free radical scavenging and antioxidant activities of silymarin components. Antioxidants (Basel). 2013 Sep;2(4):398-407. doi: 10.3390/antiox2040398, PMID 26784472.
Badnore AU, Sorde KI, Datir KA, Ananthanarayan L, Pratap AP, Pandit AB. Preparation of antibacterial peel off facial mask formulation incorporating biosynthesized silver nanoparticles. Appl Nanosci. 2019 Mar;9(2):279-87. doi: 10.1007/s13204-018-0934-2.
Parveen R, Baboota S, Ali J, Ahuja A, Vasudev SS, Ahmad S. Oil based nanocarrier for improved oral delivery of silymarin: in vitro and in vivo studies. Int J Pharm. 2011 Oct 31;413(1-2):245-53. doi: 10.1016/j.ijpharm.2011.04.041, PMID 21549187.
Chen Y, Wu Q, Zhang Z, Yuan L, Liu X, Zhou L. Preparation of curcumin-loaded liposomes and evaluation of their skin permeation and pharmacodynamics. Molecules. 2012 May 14;17(5):5972-87. doi: 10.3390/molecules17055972, PMID 22609787.
Apriani EF, Miksusanti M, Fransiska N, Fitria E, Miksusanti AM. Formulation and optimisation peel off gel mask with polyvinyl alcohol and gelatin based using factorial design from banana peel flour (Musa paradisiaca L.) as antioxidant. Indones J Pharm. 2022;32(2):261-8. doi: 10.22146/ijp.3408.
Asthana N, Pal K, Aljabali AA, Tambuwala MM, De Souza FG, Pandey K. Polyvinyl alcohol (PVA) mixed green clay and aloe vera based polymeric membrane optimization: peel off mask formulation for skin care cosmeceuticals in green nanotechnology. J Mol Struct. 2021 Apr 5;1229:129592. doi: 10.1016/j.molstruc.2020.129592.
Pereira Filho JL, Mendes AG, Campos CD, Moreira IV, Monteiro CR, Soczek SH. A comprehensive review on the antibacterial, antifungal, antiviral and antiparasitic potential of silybin. Antibiotics (Basel). 2024;13(11):1091. doi: 10.3390/antibiotics13111091, PMID 39596784.
Donadio G, Mensitieri F, Santoro V, Parisi V, Bellone ML, De Tommasi N. Interactions with microbial proteins driving the antibacterial activity of flavonoids. Pharmaceutics. 2021 May;13(5):660. doi: 10.3390/pharmaceutics13050660, PMID 34062983.
Alshehri FS, Kotb E, Nawaz M, Al Jameel S, Amin KA. Preparation, characterization and antibacterial competence of silymarin and its nano-formulation. J Exp Nanosci. 2022;17(1):100-12. doi: 10.1080/17458080.2022.2041192.
Efenberger Szmechtyk M, Nowak A, Czyzowska A. Plant extracts rich in polyphenols: antibacterial agents and natural preservatives for meat and meat products. Crit Rev Food Sci Nutr. 2021;61(1):149-78. doi: 10.1080/ 10408398.2020.1722060, PMID 32043360.
Karanje AS, Kandale JB, Jadhav R, Patil M. Formulation development and evaluation of silymarin gel. Res J Pharm Technol. 2011;4(10):1633-6.
Ali MA, Kaid BM. Development and characterization of peel-off gel masks incorporating activated charcoal and salicylic acid for enhanced skin radiance and rejuvenation. Int J Pharm Sci. 2024;2(8):3024-34. doi: 10.5281/zenodo.13294604.
Ralli T, Tripathi T, Kalaiselvan V, Tiwari R, Aeri V, Kohli K. Silymarin as a phyto-pharmaceutical: isolation, simultaneous quantification of four biomarkers and in silico anti-inflammatory activity. Chin J Anal Chem. 2023 Mar;51(3):100174. doi: 10.1016/j.cjac.2022.100174.